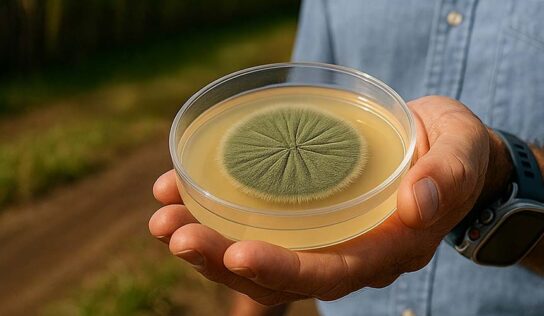
Falta de refrigeração compromete eficiência de bioinsumos no campo, alerta executivo do setor

O uso de bioinsumos no Brasil tem mostrado um crescimento significativo nas últimas décadas, especialmente na safra 2024/2025. O uso
A adoção de drones agrícolas tem transformado a forma como o agronegócio brasileiro gerencia recursos naturais e busca maior sustentabilidade